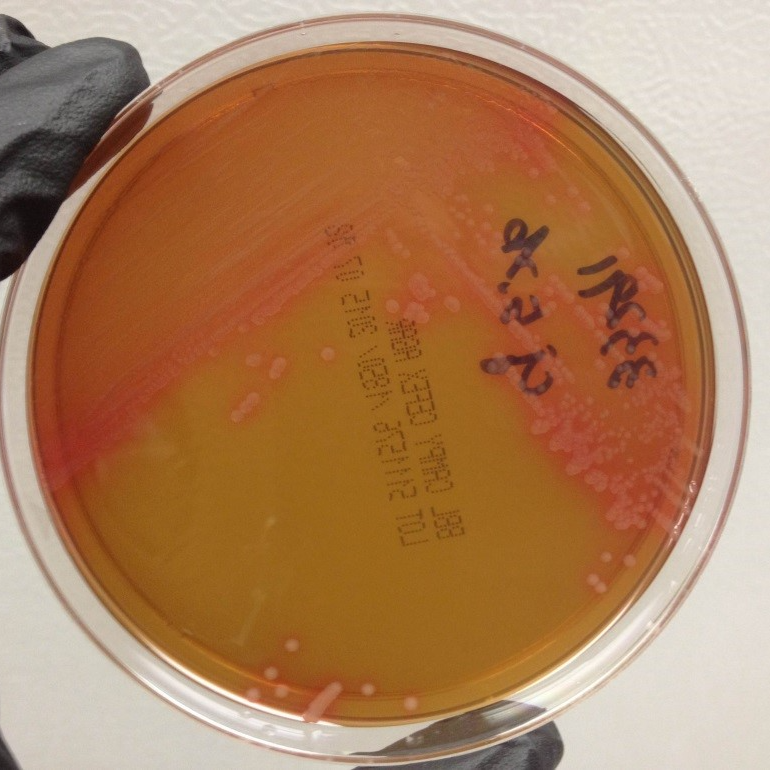
Campylobacter jejuni culture method

Feb 25, 2026
Campylobacter jejuni culture method
- Sara Lawhon1,
- Jing Wu1,
- Ching-Yuan Yang1
- 1Texas A&M University - College Station
- Vet LIRN

External link: https://doi.org/10.1177/10406387261434179
Protocol Citation: Sara Lawhon, Jing Wu, Ching-Yuan Yang 2026. Campylobacter jejuni culture method. protocols.io https://dx.doi.org/10.17504/protocols.io.kxygx91wwg8j/v1
Manuscript citation:
Lawhon SD, Cummings KJ, Wu J, Yang CY, Whipple N, Koscielny MP, Lindemann S, Kiener S, Kmet M, Reddy R, Goodman LB, Franklin-Guild RJ, Sams K, Cronk B, Cui J, Lawrence K, Zhang Q, Zhang Y, Ensley S, Olsen K, Tomaszewski J, Shen Z, Zhang S, Dasgupta S, Mann S, Patil A, Thakur S, Rankin SC, Ruesch L, Garcia-Fernandez N, Guag J, Nemser SM, Reimschuessel R (2026) Comparison of PCR and culture for detection of Campylobacter jejuni in canine feces. Journal of Veterinary Diagnostic Investigation: Official Publication of the American Association of Veterinary Laboratory Diagnosticians, Inc (). doi: 10.1177/10406387261434179
License: This is an open access protocol distributed under the terms of the Creative Commons Attribution License, which permits unrestricted use, distribution, and reproduction in any medium, provided the original author and source are credited
Protocol status: Working
This protocol is currently in use and works.
Created: February 11, 2023
Last Modified: February 25, 2026
Protocol Integer ID: 76808
Keywords: Campylobacter jejuni, culture, Bolton broth, Campy-Cefex agar, feces, dog, mCCDA, campylobacter jejuni culture method campylobacter jejuni, jejuni culture method campylobacter jejuni, campylobacter, antimicrobial susceptibility testing, antimicrobial resistance, charcoal cefoperazone deoxycholate agar, using campy, foodborne illness, important cause of foodborne illness, modified charcoal cefoperazone deoxycholate agar, culture method
Funders Acknowledgements:
U.S. Food & Drug Administration Veterinary Laboratory Investigation and Response Network
Grant ID: U18FD005013
Disclaimer
Reference to any commercial materials, equipment, or process does not in any way constitute approval, endorsement, or recommendation by the Food and Drug Administration.
The authors thank the members of the U.S. Food & Drug Administration Veterinary Laboratory Investigation and Response Network who reviewed and tested the method during multiple interlaboratory comparison exercises and blinded method tests.
Abstract
Campylobacter jejuni is an important cause of foodborne illness in humans and animals. Rapid detection of animals shedding C. jejuni is a key step in limiting the scope of outbreaks and reducing the potential exposure of humans and other animals. Culture methods are needed for the recovery of isolates for antimicrobial susceptibility testing and whole genome sequencing efforts to monitor for antimicrobial resistance. This method was developed to provide a standard method for the culture of C. jejuni from feces from veterinary patients. This culture method is based on using Campy-Cefex and modified charcoal cefoperazone deoxycholate agar supplemented with 8 mg/L cefoperazone, 4 mg/L amphotericin B, and 10 mg/L teicoplanin (mCCDA-CAT) for selection of C. jejuni.
Validation data (in-house and by an independent laboratory via collaborative study such as Randomized Blinded Method Test) are available upon request.
Image Attribution
Sara Lawhon
Guidelines
Fecal samples should be stored at Refrigerated 4-8°C until processed.
Samples should be processed within 72 hours of receipt at the laboratory.
Plates should be incubated in a microaerophilic environment at 42±2°C.
Wipe down sample tubes and gloves with 10% bleach to minimize cross-contamination.
Follow all manufacturer protocols and safety warnings for media preparation.
All fecal samples and bacterial cultures should be handled following institutional guidelines and best practices outlined in the Biosafety in Microbiological and Biomedical Laboratories (BMBL) 6th Edition from the U.S. Centers for Disease Control and Prevention (CDC).
Materials
Control Strains
ATCC 33291, ATCC 33292, or ATCC 33560Campylobacter jejuni (positive control).
ATCC 29522 E. coli (negative control)
Reagents
1X PBS Life TechnologiesCatalog #10010-023
Oxidase reagentBecton Dickinson (BD)Catalog #261181
3% hydrogen peroxideThermo Fisher ScientificCatalog # 426001000
Media
mCCDA-CAT plates - consisting of Modified Charcoal Cefoperazone Deoxycholate Agar-Cefoperazone-Amphotericin B-Teicoplanin Plates (mCCDA-CAT) made from Blood Free Campylobacter Selectivity Agar Base powder (Himedia, cat#M887) and Cefoperazone-Amphotericin B-Teicoplanin (CAT) supplement (Himedia, cat#FD145) made according to the manufacturer's protocol.
Blood Free Campylobacter Selectivity Agar BaseHimediaCatalog #M887
Cefoperazone-Amphotericin B-Teicoplanin (CAT) supplement Catalog #FD145
Campy-Cefex plates - Campy-Cefex agar platesBecton Dickinson (BD)Catalog #292487
Blood agar plates -
trypticase soy agar supplemented with 5% sheeps blood platesBecton Dickinson (BD)Catalog #221261
Supplies:
Sterile Polyester Tipped Applicators (Puritan cat#25-806 1PD)
Gas packs for maintaining a microaerophilic environment (MicroAero gas pack, Mitsubishi cat#10-05 or through ThermoFisher, cat#R681005) AnaeroPack™-MicroAero Gas GeneratorThermo FisherCatalog #R681005
Petri dishes, 100 mM, sterile, disposable for making mCCDA-CAT plates
16 mL disposable test tubes, sterile
50 mL conical tubes - sterile
Pipette tips, 1 mL
Serological pipettes, 10 mL, and 25 mL
Calibrated inoculation loops (10 µL)
Equipment needed:
Scale for weighing feces
Pipettes for appropriate volumes
Electronic serological pipette controller
Incubator capable of maintaining 42±2°C
gas-tight canister for maintaining plates under microaerophilic conditions
Protocol materials
1X PBS Life TechnologiesCatalog #10010-023
AnaeroPack™-MicroAero Gas GeneratorThermo FisherCatalog #R681005
Oxidase reagentBecton Dickinson (BD)Catalog #261181
trypticase soy agar supplemented with 5% sheeps blood platesBecton Dickinson (BD)Catalog #221261
3% hydrogen peroxideThermo Fisher ScientificCatalog # 426001000
Blood Free Campylobacter Selectivity Agar BaseHimediaCatalog #M887
Cefoperazone-Amphotericin B-Teicoplanin (CAT) supplement Catalog #FD145
Campy-Cefex agar platesBecton Dickinson (BD)Catalog #292487
Safety warnings
Follow all biosafety procedures consistent with your institution.
Campylobacter jejuni can infect and cause diarrhea in people and can cause a rare but serious complication Guillain-Barré syndrome. All materials should be handled following institutional guidelines for handling bacterial pathogens at biological safety level 2 including best practices outlined in the Biosafety in Microbiological and Biomedical Laboratories (BMBL) 6th Edition from the U.S. Centers for Disease Control and Prevention (CDC).
Background
Fecal samples should be stored refrigerated at 4 °C until processed.
Samples should be processed within 72:00:00 of receipt at the laboratory.
3d
Plates should be incubated in a microaerophilic environment at 42 °C + or - 2 .
Wipe down sample tubes and gloves with 10% bleach to minimize cross-contamination.
After isolation, identification of suspect colonies can be done by 1) sub-culturing colonies to blood agar plates for purification, incubating the plates for 48 hrs, and then performing Gram stain and biochemical tests; or 2) directly with matrix-assisted, laser desorption and ionization, time of flight (MALDI-TOF) mass spectrometry according to the manufacturer's protocol; or 3) the C. jejuni gyrA PCR [see related protocols for the PCR process: a) Extraction of DNA from canine feces for detection ofCampylobacter jejuni using the MagMaxTM CORE Nucleic Acid Purification Kit on KingFisherTM Flex Instrument; b) Extraction of DNA from canine feces for detection ofCampylobacter jejuni using MagMaxTM CORE Nucleic Acid Purification Kit on KingFisherTM DuoPrime Instrument; or c) Manual DNA Extraction Protocol for Campylobacter Detection in Canine and Bovine Feces].
Preparing the specimen
Weigh 8 g of feces from each sample into 50 mL conical tubes and record weights.
Note
Note: The amount of feces-PBS slurry is scalable at a 1:4 ratio and as little as 2 g of feces in 8 mL of 1X PBS Life TechnologiesCatalog #10010-023 can be used.
Add 32 mL of 1X PBS Life TechnologiesCatalog #10010-023 to the 8 g of feces in the 50 mL conical tube. The feces in PBS will hereafter be called the feces-PBS slurry.
Figure 1. Making the Feces-PBS slurry.
Direct Culture
Use a sterile, polyester tipped applicator (swab) to collect a small amount of feces-PBS slurry and inoculate the first quadrant of a mCCDA-CAT plate and a Campy-Cefex agar plate
and then streak for isolation.
Note
Positive control (ATCC 33291, ATCC 33292, or ATCC 33560Campylobacter jejuni) and negative control (ATCC 29522 E. coli) bacteria may be inoculated onto separate agar plates comparison.
Place plates in a gas-tight canister with a gas-generating sachet AnaeroPack™-MicroAero Gas GeneratorThermo FisherCatalog #R681005 and place in an incubator at 42 °C + or - 2 for 48:00:00 .
Note the date and time that plates are placed in the incubator.
2d
Record the date and time the plates were removed from the incubator.
Proceed to Step 20 to examine mCCDA-CAT and Campy-Cefex plates for suspect colonies.
Examining Plates and Identifying Campylobacter jejuni suspects
Examine mCCDA-CAT and Campy-Cefex plates for suspect colonies.
Colonies have a watery appearance and may have an orangish, tan color on Campy-Cefex agar (Figure 2) or colonies may be white or clear on mCCDA-CAT plates (Figure 3).
Figure 2. Campylobacter jejuni on Campy-Cefex agar.
Figure 3. Campylobacter jejuni on mCCDA-CAT agar.
Isolate up to 4 suspect colonies and subculture suspect colonies onto blood agar plates trypticase soy agar supplemented with 5% sheeps blood platesBecton Dickinson (BD)Catalog #221261
Note
For identification at the time of isolation, suspect colonies can be done by 1) sub-culturing colonies to blood agar plates for purification, incubating the plates for 48 hrs, and then performing Gram stain and biochemical tests; or 2) directly with matrix-assisted, laser desorption and ionization, time of flight (MALDI-TOF) mass spectrometry according to the manufacturer's protocol; or 3) the C. jejuni gyrA PCR [see related protocols for the PCR process: a) Extraction of DNA from canine feces for detection ofCampylobacter jejuni using the MagMaxTM CORE Nucleic Acid Purification Kit on KingFisherTM Flex Instrument; b) Extraction of DNA from canine feces for detection ofCampylobacter jejuni using MagMaxTM CORE Nucleic Acid Purification Kit on KingFisherTM DuoPrime Instrument; or c) Manual DNA Extraction Protocol for Campylobacter Detection in Canine and Bovine Feces].
Note
Colonies from the mCCDA-CAT plate are accurately identified using Bruker Biotyper MALDI-TOF without prior subculture to blood agar plates.
Place plates in a gas-tight canister with a gas-generating sachet AnaeroPack™-MicroAero Gas GeneratorThermo FisherCatalog #R681005 and place in an incubator at 42 °C + or - 2 for 48:00:00 .
Note the date and time that plates are placed in the incubator.
Record the date and time the plates were removed from the incubator.
Confirm identification of the colonies as Campylobacter species through MALDI-TOF, PCR, or biochemical testing. Campylobacter jejuni is a Gram-negative curved rod that is catalase positive and oxidase positive. The test for catalase is performed using 3% hydrogen peroxide. Oxidase testing can be performed with oxidase reagent from a variety of suppliers including
Oxidase reagentBecton Dickinson (BD)Catalog #261181
Note
Campylobacter jejuni subsp. doylei has variable catalase activity.
Protocol references
Leahy AM, Cummings KJ, Rodriguez-Rivera LD, Hamer SA, Lawhon SD. Faecal Campylobacter shedding among dogs in animal shelters across Texas. Zoonoses Public Health. 2017 Dec;64(8):623-627. doi: 10.1111/zph.12356. Epub 2017 Mar 28.
PMID: 28371319
